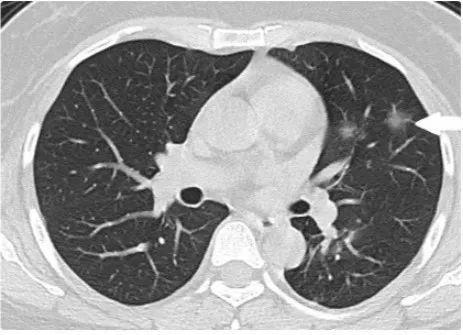

新型冠壮病毒自爆发以来,全球范围内都对其进行了广泛而深入的研究,随着病毒变异和防控措施的调整,其最新状态也引发了社会各界的关注,本文旨在探讨新型冠壮病毒的最新状态,分析当前形势下的正反方观点,并提出个人的立场及理由。
正反方观点分析
1、正方观点:新型冠壮病毒疫情得到控制,形势逐渐好转
随着全球疫苗接种率的不断提高,许多国家和地区的新型冠壮病毒疫情得到了有效控制,经济和社会生活也逐渐恢复正常,人们开始重返工作岗位和校园,科学研究也在不断取得进展,对于病毒的认识和防控措施更加精准,一些观点认为,新型冠壮病毒的威胁已经逐渐减弱。
2、反方观点:新型冠壮病毒变异加剧,防控形势依然严峻
另一些观点则持谨慎态度,病毒在不断变异,一些变异株的传染性和致病性可能更强,全球疫苗接种率不平衡,许多地区和人群尚未得到充分的保护,加之国际旅行和人员流动的增加,病毒传播的风险仍然存在,反方观点认为,新型冠壮病毒的防控形势依然严峻。
个人立场及理由
个人认为,当前新型冠壮病毒的防控形势依然严峻,需要我们保持警惕,虽然全球疫苗接种率不断提高,但病毒变异和全球接种不平衡的问题仍然不容忽视,我们还需要重视个人防护和社交距离等防控措施,以减轻病毒传播的风险。
我们也应该看到,科学研究在不断地取得进展,对于病毒的认识和防控措施更加精准,疫苗的研发和普及也为疫情防控带来了新的希望,我们应该积极采取措施,加强国际合作,共同应对疫情挑战。
新型冠壮病毒的最新状态仍然复杂多变,虽然全球疫情防控形势有所好转,但病毒变异、全球接种不平衡等问题仍然需要我们高度警惕,我们也应该看到科学研究和疫苗研发带来的希望,积极采取措施加强防控。
个人建议,应该继续加强科学研究,提高疫苗的研发和普及率,加强国际合作,共同应对疫情挑战,我们还应该坚持个人防护和社交距离等防控措施,减轻病毒传播的风险。
在未来,我们需要继续密切关注新型冠壮病毒的最新状态,根据实际情况调整防控策略,我们也需要从这次疫情中吸取教训,加强公共卫生体系建设,提高应对突发公共卫生事件的能力。
新型冠壮病毒的防控是一项长期而艰巨的任务,需要我们共同努力,我们应该保持警惕,积极应对,相信在科学和社会的共同努力下,最终一定能够战胜疫情。

京公网安备11000000000001号
京公网安备11000000000001号 京ICP备11000001号
京ICP备11000001号